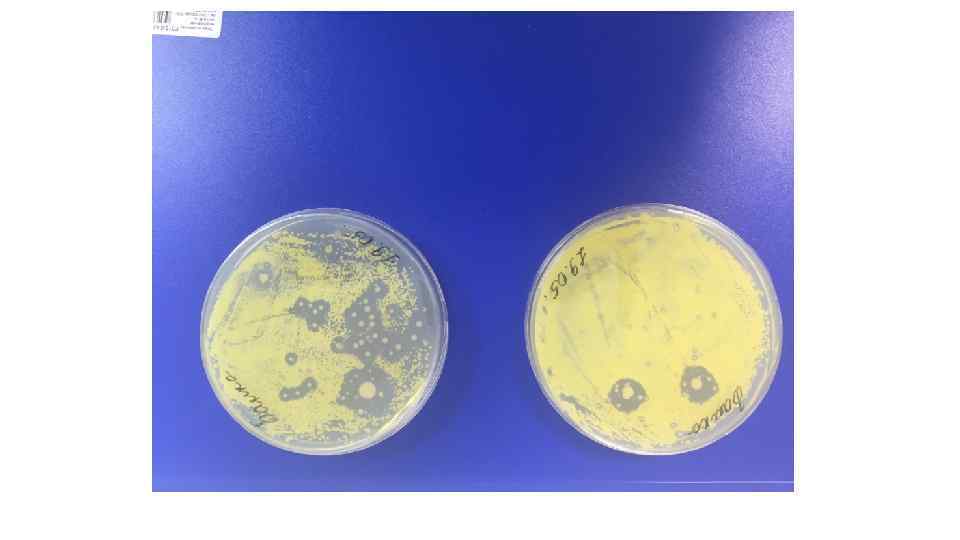

Антибиотики.pptx
- Количество слайдов: 32

Антибиотики

Классификация патогенных микоорганизмов I группа 1. Yersinia pestis - чумы II группа 1. Bacillus anthracis - сибирской язвы 2. Brucella abortus Brucella melitensis - бруцеллеза Brucella suis 3. Francisella tularensis - туляремии 4. Legionella pneumophila - легионеллеза 5. Pseudomonas mallei - сапа 6. Pseudomonas pseudomallei - мелиоидоза 7. Vibrio cholerae 01 токсигенный - холеры 8. Vibrio cholerae non 01 токсигенный - холеры

III группа • 1. Bordetella pertussis - коклюша • Mycobacterium bovis - туберкулеза • 2. Borrelia recurrentis - возвратного тифа • Mycobacterium avium • 3. Campylobacter fetus - абсцессов, септицемий • 14. Neisseria gonorrhoeae - гонорреи • 4. Campylobacter jejuni - энтерита, холецистита, • 15. Neisseria meningitidis - менингита • 16. Nocardia asteroides - нокардиоза • септицемий • 5. Clostridium botulinum - ботулизма • 17. Proactinomyces israeli - актиномикоза • 6. Clostridium tetani - столбняка • 18. Salmonella paratyphi A - паратифа A • 7. Corynebacterium diphteriae - дифтерии • 19. Salmonella paratyphi В - паратифа В • 8. Erysipelothrix rhusiopathiae - эризипелоида • 20. Salmonella typhi - брюшного тифа • 9. Helicobacter pylori - гастрита, язвенной болезни • 21. Shigella spp. - дизентерии • 22. Treponema pallidum • желудка и 12 -перстной кишки • 10. Leptospira interrogans - лептоспироза • 11. Listeria monocytogenes - листериоза • 12. Mycobacterium leprae - проказы • 13. Mycobacterium tuberculosis - сифилиса • 23. Yersinia pseudotuberculosis псевдотуберкулеза - • 24. - диареи Vibrio cholerae 01 не токсигенный • 25. Vibrio cholerae non 01 не токсигенный - диареи, раневых инфекций, септиц

IV группа 1. Aerobacter aerogenes - энтерита 2. Bacillus cereus - пищевой токсикоинфекции 3. Bacteroides spp - абсцессов легких, бактериемий 4. Borrelia spp. - клещевого спирохетоза 5. Bordetella bronchiseptica - бронхосептикоза Bordetella parapertussis - паракоклюша 6. Campylobacter spp. - гастроэнтерита, гингивита, периодонтита 7. Citrobacter spp - местных воспалительных процессов, пищевой токсикоинфекции 8. Clostridium perfringens Clostridium novyi Clostridium septicum - газовой гангрены Clostridium histolyticum Clostridium bifermentans 9. Escherichia coli - энтерита 10. Eubacterium endocarditidis - септического эндокардита

• • • • • 11. Eubacterium lentum - вторичных септицемий, абсцессов Eubacterium ventricosum 12. Flavobacterium meningosepticum - менингита, септицемий 13. Haemophilus innuenza - менингита, пневмонии, ларингита 14. Hafnia alvei - холецистита, цистита 15. Klebsiella ozaenae - озены 16. Klebsiella pneumoniae - пневмонии 17. Klebsiella rhinoscleromatis - риносклеромы 18. Mycobacterium spp. Photochromogens Scotochromogens - микобактериозов Nonphotochromogens Rapid growers 19. Micoplasma hominis 1 Micoplasma hominis 2 - местных воспалительных Micoplasma pneumoniae процессов, пневмонии 20. Propionibacterium avidum - сепсиса, абсцессов

21. Proteus spp. - пищевой токсикоинфекции, сепсиса, местных воспалительных процессов 22. Pseudomonas aeruginosa - местных воспалительных процессов, сепсиса 23. Salmonella spp - сальмонеллезов 24. Serratia marcescens - местных воспалительных процессов, сепсиса 25. Staphylococcus spp. - пищевой токсикоинфекции, септицемии, пневмонии 26. Streptococcus spp. - пневмонии, тонзиллита, полиартрита, септицемии 27. Vibrio spp. - диарей, пищевых Vibrio parahaemolyticus токсикоинфекций раневых Vibrio mimicus инфекций, септицемий и т. д. Vibrio fluviales Vibrio vulnificus Vibrio alginolyticus 28. Yersinia enterocolitica - энтерита, колита 29. Actinomyces albus - актиномикоза

Антибиотики – специфические продукты жизнедеятельности или их модификации, обладающие высокой физиологической активностью по отношению к определенным группам микрорганизмов (вирусам, бактериям, грибам, водорослям, протозоа) или к злокачественным опухолям, избирательно задерживающие их рост либо полностью подавляющие развитие. Н. С. Егоров, Основы учения об антибиотиках.

История поиска и открытия антимикробных веществ. XVI в – Парацельс, Швейцария, мышьяк, сифилис. 1909 г - Пауль Эрлих, Германия, сальварсан, сифилис. 30 -е гг XXв – сульфаниламидные препараты, сепсис, менингит, пневмония, рожистое воспаление, гонорея. 1929 г - А. Флеминг, пенициллин. 1940 – пенициллин выделен в кристаллическом виде, начало «эры антибиотиков» .

Направления поиска «Среди бактерий, актиномицетов и грибов, вероятно, нет видов, которые не проявляли бы антагонистических свойств к тем или иным микробам при тех или иных условиях роста» . И. А. Красильников, 1958 Для выделения микроорганизмов - продуцентов антибиотиков из естественных мест их обитания применяют разнообразные методы. В основу большинства приемов положен принцип выделения чистой культуры микроба и непосредственного испытания его по отношению к используемым тесторганизмам. Существенное значение при образовании антибиотических веществ имеют и смешанные культуры. Важное значение при выделении микробов, способных вырабатывать антибиотические вещества, или иной группы организмов имеет специфика условий их культивирования. Микробы - продуценты антибиотиков выделяют из субстратов, где обильно развиваются разнообразные формы микроорганизмов (бактерии, актиномицеты, дрожжи, мицелиальные грибы), поэтому очень важно знать и учитывать специфику условий развития тех организмов, которые необходимо выделить. Н. С. Егоров, Основы учения об антибиотиках.

По молекулярными механизму действия • 1) поражающие синтез бактериальной клеточной оболочки (Пенициллины, ристомицин, ванкомицин, новобиоцин, D-циклосерин и др. ); • 2) нарушающие синтез белков в бактериальной клетке (А. тетрациклиновой структуры, Макролиды, левомицетин и др. ); • 3) подавляющие синтез белков в бактериальной клетке и одновременно нарушающие считывание генетического кода в процессе трансляции (аминогликозиды); • 4) угнетающие синтез нуклеиновых кислот в клетках (Рифамицины, противоопухолевые А. ); • 5) нарушающие целостность цитоплазматической мембраны в клетках грибков (противогрибковые А. Полиены).

Резистентность микроорганизмов к антибиотикам может быть природной и приобретённой. • Истинная природная устойчивость характеризуется отсутствием у микроорганизмов мишени действия антибиотика или недоступности мишени вследствие первично низкой проницаемости или ферментативной инактивации. При наличии у бактерий природной устойчивости антибиотики клинически неэффективны. Природная резистентность является постоянным видовым признаком микроорганизмов и легко прогнозируется. • Под приобретённой устойчивостью понимают свойство отдельных штаммов бактерий сохранять жизнеспособность при тех концентрациях антибиотиков, которые подавляют основную часть микробной популяции. Возможны ситуации, когда большая часть микробной популяции проявляет приобретённую устойчивость. Появление у бактерий приобретённой резистентности не обязательно сопровождается снижением клинической эффективности антибиотика. Формирование резистентности во всех случаях обусловлено генетически: приобретением новой генетической информации или изменением уровня экспрессии собственных генов.

Известны следующие биохимические механизмы устойчивости бактерий к антибиотикам: • Модификация мишени действия. • Инактивация антибиотика. • Активное выведение антибиотика из микробной клетки (эффлюкс). • Нарушение проницаемости внешних структур микробной клетки. • Формирование метаболического «шунта» .

• Ферментативная инактивация. Наиболее распространенным механизмом устойчивости микроорганизмов к β-лактамам является их ферментативная инактивация в результате гидролиза одной из связей β-лактамного кольца ферментами β-лактамазами. К настоящему времени описано более 200 ферментов, различающихся по следующим практически важным свойствам: • Субстратный профиль (способность к преимущественному гидролизу тех или иных β-лактамов, например пенициллинов или цефалоспоринов, или тех и других в равной степени). • Локализация кодирующих генов (плазмидная или хромосомная). Эта характеристика определяет эпидемиологию резистентности. При плазмидной локализации генов происходит быстрое внутри- и межвидовое распространение резистентности, при хромосомной - наблюдают распространение резистентного клона. • Чувствительность к применяющимся в медицинской практике ингибиторам: клавулановой кислоте, сульбактаму и тазобактаму. • β-лактамазы встречаются у подавляющего большинства клинически значимых микроорганизмов, важным исключением являются микроорганизмы рода Streptococcus.

• Снижение проницаемости внешних структур бактериальной клетки является наименее специфичным механизмом устойчивости и, обычно, приводит к формированию устойчивости одновременно к нескольким группам антибиотиков. • Чаще всего причиной этого явления становится полная или частичная утрата пориновых белков. Кроме этого, относительно хорошо изучена система MAR (multiple antibiotic resistance - множественная устойчивость к антибиотикам). На фоне применения тетрациклиновили хлорамфеникола формируется устойчивость не только к этим антибиотикам, но и к β-лактамам и хинолонам. Активация MAR системы приводит к одновременному снижению количества одного из пориновых белков (Omp. F) и повышению активности одной из систем активного выведения. • Снижение проницаемости за счет утраты или снижения количества пориновых белков встречается в ассоциации с продукцией β-лактамаз расширенного спектра. Утрата одного из пориновых белков (D 2) P. aeruginosa приводит к избирательному снижению чувствительности микроорганизма к имипенему.

• Активное выведение макролидов и линкозамидов осуществляют несколько транспортных систем. Основное клиническое значение имеет система выведения, кодируемая mef-геном, распространённая среди S. pneumoniae, S. pyogenes и многих других грамположительных бактерий. Соответствующий белоктранспортер выводит 14 - и 15 -членные макролиды и обеспечивает невысокий уровень резистентности (МПК от 1 до 32 мг/л). Линкозамиды и 16 -членые макролиды сохраняют активность.

• Возбудители внебольничных инфекций • Staphylococcus spp. - устойчивость к природным и полусинтетическим пенициллинам, связанная с продукцией βлактамаз. • S. pneumoniae - устойчивость различного уровня к пенициллину (часть штаммов устойчива к цефалоспоринам III поколения), связанная с модификацией. ПСБ; высокая частота ассоциированной устойчивости к макролидам, тетрациклинам, котримоксазолу. • H. influenzae, M. catarrhalis - устойчивость к полусинтетическим пенициллинам, связанная с продукцией β-лактамаз. • N. gonorrhoeae - устойчивость к пенициллинам, связанная с продукцией β-лактамаз, устойчивость к тетрациклинам, фторхинолонам. • Shigella spp. - устойчивость к ампициллину, тетрациклинам, котримоксазолу, хлорамфениколу.

Salmonella spp. - устойчивость к ампициллину, ко-тримоксазолу, хлорамфениколу. Появление устойчивости к цефалоспоринам III поколения и фторхинолонам. E. coli - при внебольничных инфекциях МВП - возможна устойчивость к ампициллину, котримоксазолу, гентамицину. Возбудители нозокомиальных инфекций Enterobacteriaceae - продукция БЛРС (чаще всего среди Klebsiella spp. ), обуславливающая клиническую неэффективность всех цефалоспоринов; очень высокая частота ассоциированной устойчивости к гентамицину/тобрамицину; в некоторых учреждениях тенденция к росту ассоциированной резистентности к фторхинолонам, амикацину. Pseudomonas spp. , Acinetobacter spp. , S. maltophilia - ассоциированная устойчивость к цефалоспоринам, аминогликозидам, фторхинолонам, иногда карбапенемам. Enterococcus spp. - ассоциация устойчивости к пенициллинам, высокого уровня устойчивости к аминогликозидам, фторхинолонам и гликопептидам. Staphylococcus spp. (метициллинорезистентные) - ассоциированная устойчивость к макролидам, аминогликозидам, тетрациклинам, ко-тримоксазолу, фторхинолонам.

MRSA Устойчивость к ȕ-лактамным антибиотикам у MRSA опосредована ге ном mec. A, кодирующим пенициллинсвязывающий белок 2 а (PBP 2 a, или PBP 2’), который имеет меньшее сродство к ȕ-лактамам. Ген mec. A. имеет размер 2, 1 Кб и находится на мобильных генетических элементах, известных как стафилококковая хромосомная кассета mec (SCCmec). Элементы SCCmec состоят из mec-комплекса, содержащего mec. A-ген, регуляторные гены и инсерционные последовательности (IS 431, IS 1182, IS 1272); ccr-комплекса, состоящего либо из 1 (ccr. A) или 2 (ccr. A и ccr. B) сайтспецифических рекомбиназ и 3 соединительных регионов.

Механизмы резистентности к антибактериальным препаратам 1. Модификация мишени действия. 2. Инактивация антибиотика. 3. Активное выведение антибиотика из микробной клетки (эффлюкс). 4. Нарушение проницаемости внешних структур микробной клетки. 5. Формирование метаболического «шунта» .

Количество новых антибиотиков на фармацевтическом рынке* 30 % резистентных* 60 50 25 40 20 30 15 10 5 0 20 30 10 22 9 1980 1985 6 1980 -1989 1990 -1999 2000 -2009 2010 -н. в. 1995 2000 2005 2010 Метициллин-устойчивый S. aureus (MRSA) Ванкомицин-устойчивые Enterococcus spp. (VRE) Фторхинолон-устойчивые P. aeruginosa (FQRP) Ежегодно в ЕС и США внутрибольничные бактериальные инфекции приводят к более чем 100 000 смертельных случаев* *согласно данным Infectious Diseases Society of America (IDSA), Center for Disease Dynamics, Economics & Policy (CDDEP) 1990 ESKAPE - наиболее устойчивые к антибиотикам патогены Enterococcus spp. Staphylococcus aureus Klebsiella spp. Acinetobacter baumannii Pseudomonas aeruginosa Escherichia coli

Хронология открытия антибиотических препаратов (первых в своем классе): 1920 1930 1940 1950 1960 1970 1980 1990 2000 2020 2010 (КИ c 2017) (FDA, 2012) (FDA, 2011) (FDA, 2003) Около 50% случаев заболеваний внутрибольничными инфекциями связаны с грамотрицательными бактериями (Clin Infect Dis 2005; 41: 848– 854) Представители новых классов антибиотиков проявляют активность исключительно в отношении грамположительных бактерий


Устойчивость к противомикробным препаратам Информационный бюллетень ВОЗ № 194, Апрель 2015 г. Неэффективность лекарств, являющихся последним средством от гонореи — цефалоспоринам третьего поколения — подтверждена в целом ряде стран. Очень широко распространена устойчивость к фторхинолонам — одним из наиболее широко используемых противобактериальных препаратов для лечения инфекций мочевыводящих путей, вызываемых E. coli. Широко распространена устойчивость к препаратам первой линии для лечения инфекций, вызываемых Staphlylococcus aureus — распространенной причины тяжелых инфекций, приобретаемых в медицинских учреждениях и на уровне отдельных сообществ. Устойчивость представляющих угрозу для жизни инфекций, вызываемых бактериями кишечной группы, к антибиотикамкарбапенемам распространена во всех регионах мира.

Туберкулез с широкой лекарственной устойчивостью (ШЛУ-ТБ, определяемый как МЛУ-ТБ с устойчивостью к какому-либо фторхинолону и какому-либо инъекционному препарату второй линии) выявлен в 100 странах во всех регионах мира. Информационный бюллетень ВОЗ № 194, Апрель 2015 г.

Антибиотикорезистентность в России Основные возбудители нозокомиальных (внутрибольничных) инфекций Основные возбудители внебольничных инфекций • S. aureus и коагулазонегативные стафилококки • Enterococcus spp. • Семейство Enterobacteriaceae • Pseudomonas aeruginosa • Acinetobacter spp. • • Streptococcus pneumoniae Streptococcus pyogenes Haemophilus influenzae Neisseria gonorrhoeae Esherichia coli Shigella flexneri и Shigella sonnei Salmonella spp. Mycobacterium tuberculosis

Поиск новых антимикробных соединений Антибиотические свойства, проявляющиеся у многих групп микроорганизмов, обитающих в различных экологических условиях, - широко распространенное явление. Микробы – продуценты этих биологически активных веществ встречаются среди морской микрофлоры, выделяются из рек и озер, из растительных и животных остатков, непосредственно из организмов животных и растений и т. д. Однако наибольшее количество микроорганизмов, обладающих антибиотическими свойствами, обнаружено в различных почвах. Н. С. Егоров, Основы учения об антибиотиках.

Поиск новых продуцентов среди труднокультивируемых почвенных микроорганизмов 1% Uncultured diversity Culturable diversity 99% «В настоящее время известно лишь 1 -5% почвенных бактерий» . Rondon et. al. , 1999

Тейксобактин – антибиотик нового поколения

Imagining The Post-Antibiotics Future

Поиск новых продуцентов среди микроводорослей и цианобактерий

?
Антибиотики.pptx